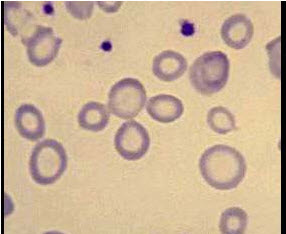

贫血患者血片如图,运铁蛋白饱和度0.12,最可能的诊断是()
A .再生障碍性贫血
B .缺铁性贫血
C .慢性感染性贫血
D .铁粒幼细胞性贫血
E .自身免疫性溶血性贫血
参考答案与解析:
-
相关试题
-
贫血患者血片如图,运铁蛋白饱和度0.12,最可能的诊断是()
-
[单选题]贫血患者血片如图,运铁蛋白饱和度0.12,最可能的诊断是()A . 再生障碍性贫血B . 缺铁性贫血C . 慢性感染性贫血D . 铁粒幼细胞性贫血E . 自身免疫性溶血性贫血
- 查看答案
-
贫血患者血片如图,运铁蛋白饱和度0.12,最可能的诊断是()<img border="0" style="width: 286px; height: 235px;&
-
[单选题]贫血患者血片如图,运铁蛋白饱和度0.12,最可能的诊断是()A.再生障碍性贫血B.缺铁性贫血C.慢性感染性贫血D.铁粒幼细胞性贫血E.自身免疫性溶血性
- 查看答案
-
贫血患者血片如图,运铁蛋白饱和度0.12,最可能的诊断是()<img border="0" style="width: 286px; height: 235px;&
-
[单选题]贫血患者血片如图,运铁蛋白饱和度0.12,最可能的诊断是()A.再生障碍性贫血B.缺铁性贫血C.慢性感染性贫血D.铁粒幼细胞性贫血E.自身免疫性溶血性
- 查看答案
-
血清运铁蛋白的饱和度是()贫血的诊断依据。
-
[单选题]血清运铁蛋白的饱和度是()贫血的诊断依据。A . 恶性B . 缺铁性C . 巨幼红细胞性D . 镰刀性
- 查看答案
-
诊断缺铁性贫血,运铁蛋白饱和度的诊断标准应该是()
-
[单选题,A1型题] 诊断缺铁性贫血,运铁蛋白饱和度的诊断标准应该是()A . <0.30B . <0.10C . <0.25D . <0.05E . <0.15
- 查看答案
-
贫血病人血片示红细胞大小不等,中心淡染,转铁蛋白饱和度13%,最可能的诊断是
-
[单选题]贫血病人血片示红细胞大小不等,中心淡染,转铁蛋白饱和度13%,最可能的诊断是A.自身免疫性溶血性贫血B.缺铁性贫血C.再生障碍性贫血D.巨幼细胞性贫血
- 查看答案
-
贫血患者,血片中红细胞大小不等,中心淡染,血清转铁蛋白饱和度14%,最可能的诊断
-
[单选题]贫血患者,血片中红细胞大小不等,中心淡染,血清转铁蛋白饱和度14%,最可能的诊断是A.自身免疫性溶血性贫血B.再生障碍性贫血C.铁粒幼细胞性贫血D.缺铁性贫血E.巨幼细胞性贫血
- 查看答案
-
下列哪项运铁蛋白饱和度的检测值,可排除缺铁
-
[单选题]下列哪项运铁蛋白饱和度的检测值,可排除缺铁A.1%B.5%C.9%D.14%E.18%
- 查看答案
-
下列哪项运铁蛋白饱和度的检测值,可排除缺铁()
-
[单选题]下列哪项运铁蛋白饱和度的检测值,可排除缺铁()A .1%B .5%C .9%D . D.14%E .18%
- 查看答案
-
贫血患者,血片中红细胞大小不等,中心淡染,血清转铁蛋白饱和度l4%,最可能的诊断
-
[单选题]贫血患者,血片中红细胞大小不等,中心淡染,血清转铁蛋白饱和度l4%,最可能的诊断是A.自身免疫性溶血性贫血B.再生障碍性贫血C.铁粒幼细胞性贫血D.缺铁性贫血E.巨幼细胞性贫血
- 查看答案
